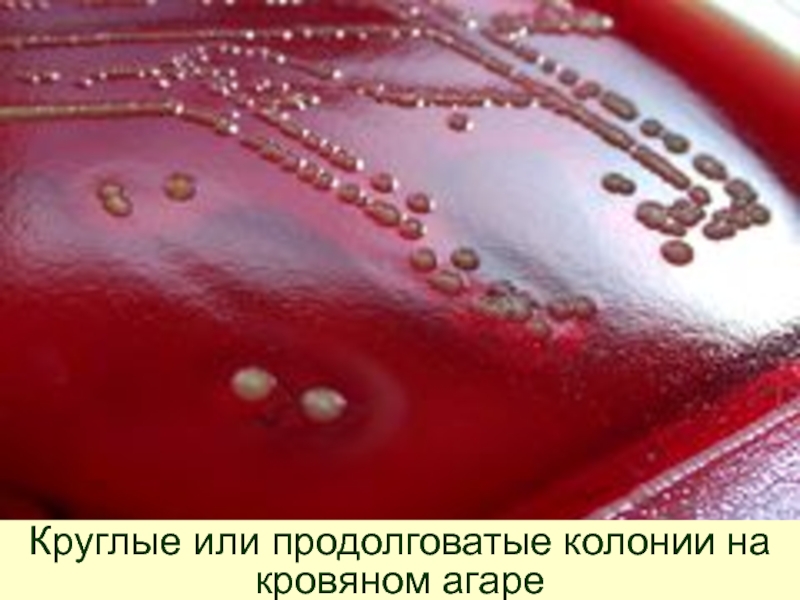
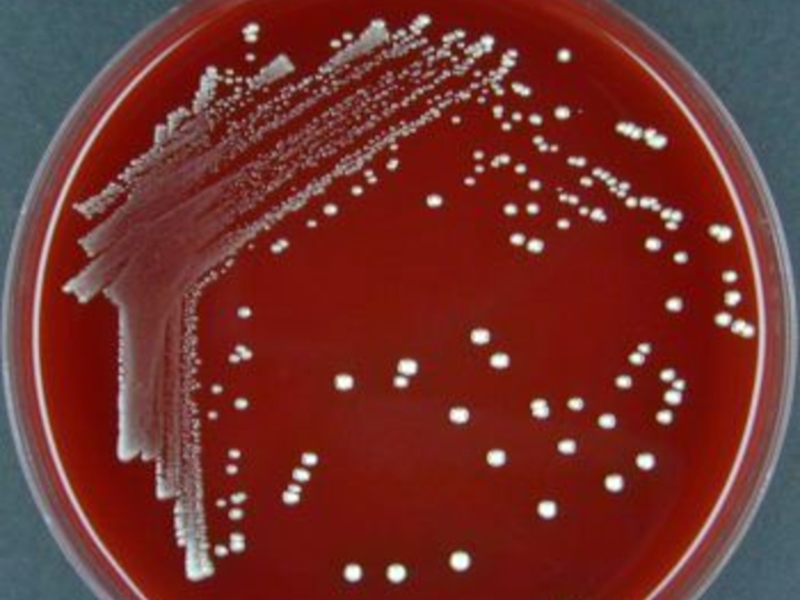

Разделы презентаций
- Разное
- Английский язык
- Астрономия
- Алгебра
- Биология
- География
- Геометрия
- Детские презентации
- Информатика
- История
- Литература
- Математика
- Медицина
- Менеджмент
- Музыка
- МХК
- Немецкий язык
- ОБЖ
- Обществознание
- Окружающий мир
- Педагогика
- Русский язык
- Технология
- Физика
- Философия
- Химия
- Шаблоны, картинки для презентаций
- Экология
- Экономика
- Юриспруденция
Институт ветеринарной медицины ФГОУ ВПО ОмГАУ Курс частной
Содержание
- 1. Институт ветеринарной медицины ФГОУ ВПО ОмГАУ Курс частной
- 2. Ф у з о б а к
- 3. ИСТОРИЧЕСКАЯ СПРАВКА, РАСПРОСТРАНЕНИЕБолезнь известна давно, но долгое
- 4. Впервые Bacterium necrophorum была выделена немецким ученым
- 5. Немецкий ученый Фридрих Лёффлер (Friedrich Loffler) в
- 6. В 1888 г. Шютц (Schutz) обнаружил бактерию
- 7. Русский ученый М.Т. Тартаковский (1895-1898) наблюдал микроорганизм,
- 8. В 1889 г. русский исследователь М.И. Поплавский
- 9. Распространен некробактериоз очень широко, особенно среди овец
- 10. А.А. Самоловов (1993) изучая данные ветеринарной отчетности
- 11. Так, с 1966 по 1970 гг. число
- 12. Широкое распространение болезни и высокая заболеваемость отмечены
- 13. При поражении конечностей у крупного рогатого скота
- 14. ВОЗБУДИТЕЛЬ Возбудитель болезни - Fusobacterium necrophorum. Синонимы:
- 15. Fusobacterium necrophorum
- 16. Грамотрицательная, неподвижная, не образующая спор и капсул палочка
- 17. Для бактерий характерна неравномерная, с промежутками, окрашиваемость
- 18. Длинные нити, окрашенные неравномерно (зернистость).
- 19. Часто такие нити имеют колбовидные и шаровидные
- 20. Колбовидные и шаровидные вздутия.
- 21. В старых культурах, а также авирулентные и
- 22. Кокковидные формы клеток.
- 23. Микроорганизм культивируют в анаэробных условиях, температурный оптимум
- 24. реже - на дне пробирки и вокруг
- 25. На плотных средах (сывороточный агар, глюкозо-кровяной агар)
- 26. Круглые или продолговатые колонии на кровяном агаре
- 27. Слайд 27
- 28. Микроорганизм широко распространен в природе, является постоянным
- 29. В водопроводной и дистиллированной воде микроб сохраняется
- 30. Э п и з о о т
- 31. Рост заболеваемости у крупного рогатого скота начинается
- 32. Источник возбудителя инфекции - больное и переболевшее
- 33. Инфицированность различных объектов внешней среды поддерживается тем,
- 34. В организм животных микроб проникает алиментарным путем
- 35. Появлению некробактериоза способствует ряд причин – травмы
- 36. Во внешней среде (в застойных лужах, болотах,
- 37. П А Т О Г Е Н
- 38. Выделяемые микроорганизмом токсические вещества нарушают функцию ферментных
- 39. Под воздействием микроорганизма коагуляционному некрозу подвергается эпителий,
- 40. Из сопутствующей микрофлоры чаще выделяют – Streptococcus,
- 41. Болезнь, в зависимости от состояния сопротивляемости организма,
- 42. При з л о к а ч
- 43. Напряженный иммунитет у переболевших некробактериозом животных не
- 44. К л и н и ч е
- 45. При спонтанном заражении можно выделить следующие формы
- 46. Воспалительный отек, выражается припуханием кожи и повышением местной температуры.
- 47. Воспалительный отек сжимает нервные окончания и вызывает
- 48. Подергивание конечностью.
- 49. Животное держит конечность навесу.
- 50. В последующие дни идет формирование абсцесса с
- 51. Нарастание отечности, болезненности и хромоты
- 52. При поверхностном подкожном его расположении абсцесс формируется
- 53. Абсцесс вскрывается и образуется язва.
- 54. Абсцесс вскрывается и образуется язва.
- 55. Чаще всего процесс распространяется в разные стороны,
- 56. Язвенная поверхность, покрыта серовато-грязным, вязким или жидким гноем со специфическим запахом.
- 57. В случае нахождения первичной язвы в близи
- 58. Флегмона венчика
- 59. Флегмона венчика
- 60. После вскрытия флегмоны образуется один или несколько
- 61. Свищевой канал под роговой башмак.
- 62. Распространяясь, процесс проникает глубже под роговой башмак
- 63. Артрит копытцевого сустава
- 64. Артрит путового сустава.
- 65. Артрит
- 66. Далее происходит отслоение рогового башмака от копытцевой
- 67. Гнойно-некротический распад суставного хряща и костной ткани.
- 68. Гнойный остеоартрит.
- 69. Первичный некробактериозный очаг может появиться в коже
- 70. Флегмона мякиша пальца.
- 71. Флегмона мякиша пальца.
- 72. Флегмона мякиша пальца.
- 73. Флегмона мякиша пальца.
- 74. При локализации очага в коже межпальцевой складки
- 75. Флегмона свода межкопытцевой щели.
- 76. Флегмона свода межкопытцевой щели.
- 77. Далее формируется абсцесс, происходит его вскрытие и образование гнойно-некротической язвы.
- 78. Гнойно-некротическая язва в области межкопытцевой щели.
- 79. Гнойно-некротическая язва в области венчика и межкопытцевой щели
- 80. Гнойно-некротическая язва в области венчика и межкопытцевой щели
- 81. В случае воспаления основы кожи копыта со
- 82. Животное вытягивает больную конечность вперед.
- 83. Или держит больную конечность навесу.
- 84. или опирается на зацепной участок копыта.
- 85. У животного отмечается мышечная дрожь, повышение общей
- 86. Припухлость флегмонозного типа, образование абсцесса.
- 87. Гнойный пододерматит, вскрытие абсцесса.
- 88. Гнойный пододерматит, вскрытие абсцесса.
- 89. Гнойный пододерматит, вскрытие абсцесса.
- 90. Следует отметить, что деление признаков по отдельным
- 91. Клинически хроническая форма болезни проявляется болезненностью конечности,
- 92. При длительном течении болезни животное заметно худеет
- 93. Некробактериозные поражения слизистой оболочки ротовой полости. Эта
- 94. При осмотре ротовой полости на губах, деснах,
- 95. На языке - глубокие гнойно-некротические язвы, покрытые сероватыми дифтеретическими пленками.
- 96. На языке - гнойно-некротические язвы.
- 97. Нектобактериоз верхней челюсти и языка у телёнка (дифтерия)
- 98. Налеты могут перейти на гортань, трахею и
- 99. Дифтеретические налеты на гортани.
- 100. Некробактериоз половых органов. Коровы заболевают чаще в первые
- 101. Процесс может распространяться на матку. Больные животные
- 102. Некротические очаги на вымени.
- 103. Некротические очаги на вымени.
- 104. Поражения полового аппарата самцов. Болезнь выражается в
- 105. Обычно воспаление этих тканей диагностируют как баланопостит.
- 106. Поскольку моча задерживается в препуциальном мешке, она
- 107. Некробактериозные поражения хвоста. При осмотре хвостов отмечают
- 108. Некробактериоз внутренних органов. Чаще поражаются печень, легкие,
- 109. Патологоанатомические изменения. У крупного рогатого скота возможны
- 110. При разрезе такого участка обнаруживают гнойно-некротический распад
- 111. Патологоанатомическим изменениям на конечностях могут сопутствовать изменения
- 112. В печени - абсцессы, очаги некроза
- 113. В печени - абсцессы, очаги некроза
- 114. В печени - абсцессы, очаги некроза
- 115. В печени - абсцессы, очаги некроза
- 116. В печени - абсцессы, очаги некроза
- 117. В легких - абсцессы, очаги некроза
- 118. В сердечной мышце - некротические очаги, кровоизлияния на эпи- и эндокарде.
- 119. При вовлечении в процесс рубца, книжки, сетки,
- 120. Гнойно-некротическое воспаление в кишечнике.
- 121. ДИАГНОЗ Первичный диагноз на некробактериоз при поражении
- 122. Для лабораторного исследования берут материал на границе
- 123. Отбор материала для бакисследований.
- 124. Дифференциальный диагноз Некробактериоз необходимо дифференцировать у крупного
- 125. ЛЕЧЕНИЕ При кожной форме болезни лечение начинают
- 126. Затем проводят собственно хирургическую обработку с удалением
- 127. После хирургической обработки на очаг поражения наносят
- 128. Препарат фиксируют легкой ватно-марлевой повязкой. Первую перевязку
- 129. ИММУНИТЕТ И ИММУНОПРОФИЛАКТИКА. Животные, переболевшие некробактериозом, иммунитет
- 130. ВАКЦИНА ИНАКТИВИРОВАННАЯ АССОЦИИРОВАННАЯ ПРОТИВ НЕКРОБАКТЕРИОЗА КОНЕЧНОСТЕЙ КРУПНОГО РОГАТОГО СКОТА «НЕКОВАК» ВАКЦИНА ПРОТИВ НЕКРОБАКТЕРИОЗА ЖИВОТНЫХ ИНАКТИВИРОВАННАЯ
- 131. ПРОФИЛАКТИКА И МЕРЫ БОРЬБЫ. Для профилактики некробактериоза
- 132. Обработка конечностей животных в ваннах
- 133. Обработка конечностей животных в ваннах
- 134. Животноводческую ферму (бригаду отделение, хозяйство), в которой
- 135. В неблагополучном по некробактериозу стаде всех больных
- 136. Принимают меры к устранению всех возможных мест
- 137. В животноводческих помещениях, скотопрогонах, доильных залах проводят
- 138. НЕКРОБАКТЕРИОЗ ЧЕЛОВЕКАЗаражение человека происходит через микротравмы на
- 139. Продолжительность инкубационного периода 3 - 8 дней.
- 140. БЛАГОДАРЮ ЗА ВНИМАНИЕ! 04.08.2011 г.Презентацию подготовил д.в.н., профессор И.Г. Трофимов
- 141. Скачать презентанцию
Ф у з о б а к т е р и о з (1980) - инфекционная болезнь животных, характеризующаяся гнойно-некротическими поражениями кожи и подлежащих тканей преимущественно конечностей, реже морды и вымени,
Слайды и текст этой презентации
Слайд 2Ф у з о б а к т е р
и о з (1980) - инфекционная болезнь животных, характеризующаяся гнойно-некротическими
поражениями кожи и подлежащих тканей преимущественно конечностей, реже морды и вымени, слизистых оболочек ротовой полости, половых и внутренних органов.Слайд 3ИСТОРИЧЕСКАЯ СПРАВКА, РАСПРОСТРАНЕНИЕ
Болезнь известна давно, но долгое время ее описывали
под разными названиями:
у северных оленей - это копытка, копытница,
копытная болезнь; у лошадей - гангренозный дерматит, гангренозный мокрец, эпизоотическая гангрена, инфекционный дерматит;
у овец - копытная гниль, копытная болезнь овец, панарициум.
Слайд 4Впервые Bacterium necrophorum была выделена немецким ученым Р. Кохом (R.
Koch) в 1881г. из изъязвленной роговицы барана.
Слайд 5
Немецкий ученый Фридрих Лёффлер (Friedrich Loffler) в 1882 г. подробно
описал данный микроорганизм, выделенный от телят больных "дифтерией".
Слайд 6В 1888 г. Шютц (Schutz) обнаружил бактерию в гнойно-некротических очагах
печени коровы.
И. Шморль (I. Schmorl)
в 1891 г. описала
аналогичный микроб выделенный от больных кроликов. Слайд 7Русский ученый М.Т. Тартаковский (1895-1898) наблюдал микроорганизм, имевший вид длинных
нитей, в содержимом абсцессов из печени телят, а позднее -
у больных кроликов.В чистой культуре Bac. necrophorum впервые получена датским исследователем Б. Бангом
(B.Bang) в 1890 г.
Слайд 8В 1889 г. русский исследователь М.И. Поплавский высказал предположение, что
некротические процессы в области путовых суставов и венчика лошадей вызываются
Bac. necrophorum.И.В. Попов (1929) пришел к выводу, что причиной массовых заболеваний копыт у овец является Bac. necrophorum.
Немецкий ученый Х. Хаупт (H. Haupt) в 1925 году объединил болезни животных разных видов, вызываемые бактерией некроза, под названием "некробациллёзы".
Слайд 9Распространен некробактериоз очень широко, особенно среди овец и северных оленей;
практически, где есть животные этих видов, там есть и некробактериоз.
Но с 70-тых годов прошлого столентия, с введением новых промышленных технологий в скотоводство и свиноводство, некробактериоз стал серьезной проблемой у крупного рогатого скота и свиней.Слайд 10А.А. Самоловов (1993) изучая данные ветеринарной отчетности о распространении некробактериоза
у крупного рогатого скота в Новосибирской области за 20-ти летний
период (1960-1980 гг.) отмечал, что в начале 60-х годов болезнь регистрировали лишь в отдельных пунктах, а число больных животных исчислялось единицами, но в конце 60-х годов наметилась тенденция к распространению инфекции.Слайд 11Так, с 1966 по 1970 гг. число неблагополучных пунктов увеличилось
с 4 до 20, численность больных в одном неблагополучном пункте
повысилась почти в два раза, выбраковка и сдача заболевших животных составляла в отдельные годы от 52,5 до 65,4%.Слайд 12Широкое распространение болезни и высокая заболеваемость отмечены и в Омской
области в первой половине 70-х годов. Практически некробактериоз зарегистрирован во
всех районах области, а в неблагополучном пункте насчитывалось в среднем 120-190 больных животных.Слайд 13При поражении конечностей у крупного рогатого скота экономический ущерб проявляется
за счет снижения продуктивности животными (снижение удоя на 5,3 кг
в сутки, массы тела - до 50 кг в месяц, увеличение по времени периода от отёла до охоты на 17 суток, а от отёла - до оплодотворения - на 30 суток). Кроме того, значительный ущерб несут хозяйства от вынужденного убоя больных животных, утилизации продуктов убоя, молока; затрат на лечение и дезинфекцию.Слайд 14ВОЗБУДИТЕЛЬ
Возбудитель болезни - Fusobacterium necrophorum. Синонимы: Bacterium diphteria vitulorum
(Loffler, 1882), Actinomyces necrophorum (Flugge, 1884), Necrosebacillus (Bang, 1890) и
т.п..Fusobacterium necrophorum - строгий анаэроб, грамотрицательная, неподвижная, не образующая спор и капсул палочка, полиморфная, способная принимать причудливые формы.
Слайд 17Для бактерий характерна неравномерная, с промежутками, окрашиваемость обычными анилиновыми красителями.
Микробы хорошо красятся фуксином Циля и синькой Лефлера, а также
по Муромцеву.В молодых культурах и в мазках из некротических очагов микроорганизм располагается в форме длинных нитей, окрашиваемых неравномерно (зернистость).
Слайд 19Часто такие нити имеют колбовидные и шаровидные вздутия, окрашивающиеся более
интенсивно и значительно превосходящие толщину нитей. Иногда нити - гладкие
и равномерно окрашены.Слайд 21В старых культурах, а также авирулентные и слабовирулентные штаммы имеют
форму стройных небольших палочек, часто по концам окрашенных более интенсивно
(биполярно).В таких культурах встречаются и кокковидные формы клеток.
Слайд 23Микроорганизм культивируют в анаэробных условиях, температурный оптимум - 37С. Хороший
рост дает на среде Китта-Тароци, сывороточном и глюкозо-кровяном агаре.
На
среде Китта-Тароци с глюкозой через 24-48 часов образуется помутнение среды и хлопьевидный осадок на кусочках печени; Слайд 24реже - на дне пробирки и вокруг кусочков печени появляется
облачкообразное помутнение, увеличивающееся через 2-4 дня;
под вазелиновым маслом, покрывающим
среду, образуются пузырьки газа; среда просветляется через 8-10 дней, выпадает крошковатый осадок.
Слайд 25На плотных средах (сывороточный агар, глюкозо-кровяной агар) в анаэробных условиях
через 2-3 суток образуются мелкие круглые или продолговатые колонии.
В
культурах на плотных средах бактерии образуют гемолизин, на жидких - токсин. Слайд 28Микроорганизм широко распространен в природе, является постоянным обитателем кишечника животных.
К факторам внешней среды микроорганизм не устойчив:
погибает в течение
15-ти минут при нагревании до 65С, мгновенно - при кипячении. Высушенные при доступе воздуха культуры теряют жизнеспособность через 72 часа.
Культуры, подвергшиеся замораживанию, выживают в течение 30-40 дней.
Слайд 29В водопроводной и дистиллированной воде микроб сохраняется до 15-ти суток,
в молоке - до 35 суток,
в физиологическом растворе -
до 45 суток, в моче - 15 суток,
в фекалиях - до 50 суток.
Fusobacterium necrophorum очень чувствительна к антибиотикам тетрациклинового ряда.
Из лабораторных животных к микроорганизму наиболее восприимчивы кролики и белые мыши.
Слайд 30Э п и з о о т о л о
г и я
К некробактериозу восприимчивы все виды сельскохозяйственных животных,
птицы и многие дикие животные. В порядке уменьшения восприимчивости к возбудителю стоят северные олени, крупный рогатый скот, свиньи, лошади.
Некробактериоз описан у кроликов, собак, кошек, многих диких животных.
Болеет и человек.
Слайд 31Рост заболеваемости у крупного рогатого скота начинается после постановки животных
на стойловое содержание, и продолжается в последующие месяцы, с пиком
в марте-апреле, оставаясь высоким до мая-июня, и только с выгоном на пастбищное содержание наступает резкий спад.Слайд 32Источник возбудителя инфекции - больное и переболевшее животное. Кроме того
установлено микробоносительство здоровыми животными. В частности микроб удается выделить из
содержимого рубца оленей в 87%-тах случаев.Возбудитель инфекции попадает во внешнюю среду с некротизированной тканью из кожных язв и открытых полостей, а так же с фекалиями.
Слайд 33Инфицированность различных объектов внешней среды поддерживается тем, что бактерии некроза
постоянно присутствуют и вегетируют в желудочно-кишечном тракте животных и грызунов.
Жуки-навозники, питающиеся калом животных-бактерионосителей, в 39,9% случаев содержат в себе возбудителя некробактериоза.
Слайд 34В организм животных микроб проникает алиментарным путем (с кормом или
водой) через повреждения слизистых оболочек, а также - при нарушении
целостности кожи, мацерации ее. Новорожденные заражаются через пуповину. Некробактериоз половых путей развивается в результате повреждений слизистой оболочки при случке или тяжелых родах.Инфекция проявляется в виде единичных случаев или эпизоотий.
Слайд 35Появлению некробактериоза способствует ряд причин – травмы конечностей или слизистых
оболочек ротовой полости, низкое санитарно-гигиеническое состояние помещений (влажность, сырость, навоз
и др.), неполноценное кормление, а также недостаток витаминов и минеральных веществ в рационе.Слайд 36Во внешней среде (в застойных лужах, болотах, увлажненных пастбищах, куда
попадает возбудитель инфекции с выделениями животных, особенно, с навозом) возбудитель
остается жизнеспособным в течение 90 суток.Слайд 37П А Т О Г Е Н Е З
Некробактериоз
представляет собой типичную послераневую инфекцию. Возбудитель, попав в травмированные ткани,
бурно размножается в них, т.к. создаются условия анаэробиоза вследствие нарушения целостности капилляров и недостаточного снабжения кислородом тканей.Слайд 38Выделяемые микроорганизмом токсические вещества нарушают функцию ферментных систем, участвующих в
клеточном обмене, вызывают спазм капилляров, что приводит к нарушению притока
крови к пораженному участку.Кроме того, активно размножа-ющиеся микробы механически закупоривают мелкие сосуды.
Слайд 39Под воздействием микроорганизма коагуляционному некрозу подвергается эпителий, соединительные ткани, подкожный
слой, надкостница, кости.
При этом они находятся на границе между
пораженной и живой тканью. Некротический процесс опережает рост клеток в зоне демаркационного воспаления, поэтому вокруг очага нет капсулы и некроз прогрессирует, а обитающие в местах поражения различные микроорганизмы усугубляют этот процесс.
Слайд 40Из сопутствующей микрофлоры чаще выделяют – Streptococcus, Staphilococcus, Cl. oedematiens,
Cl. septicum, Cl. perfringens E. сoli и Micrococcus, большинство из
которых оказываются высоковирулентными.Возникают очаги коликвационного гнойно-гнилостного распада - ткань превращается в полужидкую массу со зловонным запахом.
Слайд 41Болезнь, в зависимости от состояния сопротивляемости организма, может протекать доброкачественно
и злокачественно.
При д о б р о к а
ч е с т в е н н о м течении (если организм не ослаблен) на границе некротизированного участка развивается реактивное воспаление. Лейкоциты и макрофаги, вызывая рассасывание мертвого субстрата, предохраняют живую ткань и, следовательно, весь организм от всасывания ядовитых продуктов распада ткани и токсинов бактерий из некротического очага. При таком течении процесса некротический участок инкапсулируется и отторгается, а дефект замещается соединительной тканью.
Слайд 42При з л о к а ч е с т
в е н н о м течении - некротический процесс
распространяется на соседние ткани. Вторичные очаги некроза появляются в прилегающих здоровых тканях: в коже, сухожилиях, костях.Микробы проникают в кровь, развивается септицемия. Инфицированные тромбы разносятся током крови и оседают в капиллярах внутренних органов. Возникают некротические очаги в сердце, печени, легких. Развиваются признаки общей интоксикации: лихорадка, угнетение, учащение пульса, морфологические и биохимические изменения в крови, функциональные нарушения отдельных внутренних органов.
Слайд 43Напряженный иммунитет у переболевших некробактериозом животных не развивается, но признаки
клеточного иммунитета (Т-лимфоциты, макрофаги, лимфоциты, плазмоциты) присутствуют в регионарном месту
поражения лимфатическом узле.Слайд 44К л и н и ч е с к и
е п р и з н а к и
В 1935 г. С.Н. Муромцев предложил классификацию клинических форм болезни по месту локализации процесса с выделением трех форм:
кожная, предусматривающая преимущественно поражение кожи в области конечностей;
некробактериоз слизистых оболочек и некробактериоз внутренних органов.
Позднее Я.Р. Коваленко наряду с этим отдельно выделил:
некробактериозный остит и остеомиелит.
Слайд 45При спонтанном заражении можно выделить следующие формы и признаки болезни.
Некробактериозные
поражения конечностей.
Возбудитель некробактериоза, проникнув через механически поврежденную или мацерированную
кожу, размножаясь, ведет к образованию воспалительного отека, что выражается припуханием кожи и повышением местной температуры. Слайд 47Воспалительный отек сжимает нервные окончания и вызывает болезненность. Животное начинает
периодически подергивать конечностью, как бы пытаясь сбросить кусок прилипшей грязи,
или приподнимает конечность и некоторое время держит ее навесу, а затем начинает кратковременно вновь опираться .Слайд 50В последующие дни идет формирование абсцесса с нарастанием отечности, болезненности
и хромоты.
В это время у животных температура тела поднимается
выше нормы или повышается по сравнению с исходной до начала заболевания. Слайд 52При поверхностном подкожном его расположении абсцесс формируется в течение 5-7
дней, затем он вскрывается и образуется язва.
В отдельных случаях
через 12-15 дней язва самопроизвольно эпителизируется и животное выздоравливает. Слайд 55Чаще всего процесс распространяется в разные стороны, дно язвы углубляется,
образуется обширная язвенная поверхность, покрытая серовато-грязным, вязким или жидким гноем
со специфическим запахом.Слайд 56Язвенная поверхность, покрыта серовато-грязным, вязким или жидким гноем со специфическим
запахом.
Слайд 57В случае нахождения первичной язвы в близи венечного края развивается
так называемая флегмона венчика.
Венчик шарообразно или циркулярно выдается над
роговым башмаком, упругий, горячий и болезненный. Местная температура повышается на несколько градусов, отмечается сильная болезненность, резко выраженная хромота. Слайд 60После вскрытия флегмоны образуется один или несколько свищевых каналов по
направлению сверху вниз под роговой башмак.
Болезнь прогрессирует, распространяется на
околосуставные ткани и развивается параартикулярная флегмона. Пораженный палец значительно утолщается, обнаруживается обширная язвенная поверхность, покрытая серовато-бурым пенистым гноем с ихорозным запахом.
Слайд 62Распространяясь, процесс проникает глубже под роговой башмак копытца, начинается распад
основы кожи и капсулы копытцевого сустава, гнойно-некротический процесс осложняется артритом
копытцевого сустава.В этом случае больной палец значительно утолщен (1,5-2 раза), кожа горячая на ощупь, что указывает на повышение местной температуры. Отмечается болезненность и резко выраженная хромота, животное мало двигается и больше лежит.
Слайд 66Далее происходит отслоение рогового башмака от копытцевой кости и интенсивный
гнойно-некротический распад суставного хряща и костной ткани, что характерно уже
для гнойного остеоартрита.Слайд 69Первичный некробактериозный очаг может появиться в коже межпальцевой складки, мякиша
и других участках пальца. Воспалительный процесс протекает подобно описанному выше.
При поражении мякиша возникают признаки флегмоны мякиша, который резко увеличен в объеме, становится плотным, болезненным. Формирование абсцесса продолжается 5-7 дней.Слайд 74При локализации очага в коже межпальцевой складки появляются признаки гнойного
воспаления, как при флегмоне свода межкопытцевой щели. Кожа становится набухшей,
горячей, болезненной.На ее поверхности могут появиться капли клейкого выпота. Межкопытцевая щель расширена.
Слайд 81В случае воспаления основы кожи копыта со стороны медиальной стенки
или подошвы, что бывает чаще, возникают признаки гнойного пододерматита. Формирование
абсцесса сопровождается сильной болезненной реакцией.Слайд 85У животного отмечается мышечная дрожь, повышение общей температуры тела.
Затем
в пяточной части появляется припухлость флегмонозного типа, образование и вскрытие
абсцесса.Слайд 90Следует отметить, что деление признаков по отдельным диагнозам условное. Они
редко присутствуют в чистом виде, так как воспалительный процесс находится
в развитии, вовлекая все новые ткани и формируя новые признаки.Слайд 91Клинически хроническая форма болезни проявляется болезненностью конечности, хромотой, при движении
животное не опирается на больную конечность.
Следует отметить, что при
длительном течении болезни животное заметно худеет.Слайд 93Некробактериозные поражения слизистой оболочки ротовой полости.
Эта форма болезни часто
регистрируется у молодняка. Заподозрить животных в заболевании можно по выделению
изо рта пенисто-тягучей слюны гнилостного запаха. Животные неохотно отзываются на кормление, аппетит постоянно уменьшается, больные больше лежат.Слайд 94При осмотре ротовой полости на губах, деснах, щеках или языке
обнаруживают глубокие гнойно-некротические язвы, покрытые сероватыми дифтеретическими пленками, со свищевыми
ходами.При отторжении наложений остаются темно-красные легко кровоточащие, противно пахнущие язвы.
Слайд 95На языке - глубокие гнойно-некротические язвы, покрытые сероватыми дифтеретическими пленками.
Слайд 98Налеты могут перейти на гортань, трахею и полость носа. При
развитии некротического процесса на слизистой оболочке щек и десен могут
наступить периодонтит и периостит с последующим выпадением зубов.Поражение слизистых оболочек может быть и у взрослых животных. Оно чаще носит доброкачественный характер и часто заканчивается сомовыздоровлением, тогда как заболевшие молодые животные погибают через 7-10 суток, иногда болезнь затягивается до 2-3 недель.
Слайд 100Некробактериоз половых органов.
Коровы заболевают чаще в первые дни после отела.
Влагалище и срамные губы опухают. Трещины и раны влагалища, наблюдаемые
после отела, быстро принимают серый вид. Через 1-2 дня размеры поражений увеличиваются, они покрываются серым, серовато-красным или черно-красным слоем мертвой ткани. Вонючее истечение из влагалища сначала незначительное, затем постоянно увеличивается и достигает максимума через 5-10 дней.Слайд 101Процесс может распространяться на матку. Больные животные часто натуживаются и
стонут.
Болезнь может наблюдаться также в последнем периоде стельности. Первые
признаки – аборта замечают на 8-9-ом месяце стельности. У некоторых животных плод мумифицируется и появляется наружу после обильного истечения неприятно пахнущей ихорозной жидкости. После аборта послед долго не отделяется.
Слайд 104Поражения полового аппарата самцов.
Болезнь выражается в виде появления мелких
пятен бледного цвета на коже крайней плоти и на слизистой
оболочке полового члена. Пятна вскоре превращаются в язвы, увеличиваясь, они сливаются между собой. Иногда вся поверхность препуция покрывается язвами.Слайд 105Обычно воспаление этих тканей диагностируют как баланопостит. Болезнь проявляется изъязвлением
кожи вокруг препуциального отверстия.
Из препуциального мешка выделяется серозно-гнойный экссудат,
происходит склеивание в пучки волосков, окружающих препуциальное отверстие. По этой причине мечеиспускание затруднено, моча вытекает мелкими каплями.
Слайд 106Поскольку моча задерживается в препуциальном мешке, она вовлекается в воспалительный
процесс, разжижает гнойный экссудат. Препуциальный мешок увеличивается в объеме, в
нем скапливается большое количество серовато-бурого экссудата с гнилостным запахом. На поверхности препуциального мешка и полового члена образуются язвенные поражения. Вскоре воспалительный процесс захватывает брюшину, развивается перитонит, и животное погибает.Слайд 107Некробактериозные поражения хвоста.
При осмотре хвостов отмечают отечность основания на
высоту 5-10 см, кончик покрыт сухой темно-коричневой корочкой или концевые
волосы слипшиеся в комок. У отдельных животных выше места отечности видны язвочки, распространяющиеся циркулярно.Когда процесс охватывает весь диаметр, пораженная часть отторгается и процесс отторжения повторяется. В затяжном случае возможно распространение воспаления до репицы.
При продольном разрезе отечной части ампутированного хвоста отмечают абсцессы разной величины, заполненные густым беловатым гноем, нередко разлитое флегмонозно-гнойное воспаление без демаркационной линии.
Слайд 108Некробактериоз внутренних органов.
Чаще поражаются печень, легкие, селезенка, почки.
Однако
симптомокомплекс болезни бывает не характерен. Возможно лишь появление признаков, свойственных
поражению того или иного органа.Изменения во внутренних органах в основном выявляют при убое животных или их гибели, они обычно представлены абсцессами разной величины.
Слайд 109Патологоанатомические изменения.
У крупного рогатого скота возможны некротические поражения всех
частей тела.
В практических же условиях в основном выявляют поражения
конечностей, как наиболее легко поддающиеся диагностике. На дистальном участке конечности устанавливают значительное утолщение пораженного пальца с различными по размерам дефектами кожи и подлежащих тканей.
Слайд 110При разрезе такого участка обнаруживают гнойно-некротический распад тканей с ихорозным
запахом тканевого детрита с буровато-коричневым полужидким гноем.
Вокруг очага поражения
- интенсивное разрастание соединительной ткани, сочной и блестящей на разрезе, местами с небольшими кровоизлияниями или инкапсулированными гнойниками. Слайд 111Патологоанатомическим изменениям на конечностях могут сопутствовать изменения в органах грудной,
брюшной, ротоглоточной, носовой полостях, но бывает и без них.
В
печени и легких находят абсцессы, очаги некроза и кровоизлияния. В сердечной мышце - некротические очаги, кровоизлияния на эпи- и эндокарде.
При поражении ротовой полоски и глотки - гнойно-некротический и гнойно-фибринозный стоматит, тонзилит, периостит, периодонтит и глубокие язвы.
Слайд 119При вовлечении в процесс рубца, книжки, сетки, сычуга и кишечника
- ограниченное гнойно-некротическое воспаление, язвы.
При поражении половых органов задняя
часть тела у самок испачкана гнилостными истечениями. Во влагалище - хлопьевидные грязно-серые наложения, слизистая оболочка отёчная и гангренозная, местами покрыта язвами. Матка увеличена, заполнена гнойно-фибринозной массой, на слизистой оболочке и в толще обнаруживают гнойные наложения. Слайд 121ДИАГНОЗ
Первичный диагноз на некробактериоз при поражении дистального отдела конечностей,
кожного покрова и слизистых оболочек ставят на основании клинических признаков и
учетом эпизоотологических данных, а именно, массовая заболеваемость животных с однотипными признаками. Характерным считается наличие гнойно-некротических поражений с гнилостным специфическим запахом.Слайд 122Для лабораторного исследования берут материал на границе пораженной и здоровой
ткани. Из отобранных тканей делают мазки и окрашивают по Граму,
Муромцеву, Романовскому-Гимза или синькой Лёфлера.Высевы из патологического материала делают на среду Китта-Тароцци, амино-кровин-желточно-сывороточный (АКЖСА) или сывороточно-глюкозный агар (СГА).
Одновременно с этим суспензией патологического материала заражают белых мышей или кроликов.
Слайд 124Дифференциальный диагноз
Некробактериоз необходимо дифференцировать у крупного рогатого скота -
от чумы, контагиозной плевропренвмонии, злокачественной катаральной горячки, стоматитов и дерматитов
инфекционной природы.Слайд 125ЛЕЧЕНИЕ
При кожной форме болезни лечение начинают с механической и
антисептической подготовки окружности и очага воспаления, что достигается обмыванием от
загрязнений с помощью 0,1-0,5%-го раствора перманганата калия, 0,5-2,0%-го хлорамина или других слабых растворов дезинфицирующих средств.Слайд 126Затем проводят собственно хирургическую обработку с удалением омертвевших тканей, гноя,
устранением затеков, ниш и карманов. В заключении рану орошают 3%-м
раствором перекиси водорода и обсушивают ватно-марлевым тампоном.Для полного очищения раны от гноя и мертвых тканей можно применить протеолитический фермент профезим, согласно наставлению по его применению.
Слайд 127После хирургической обработки на очаг поражения наносят один один из
антисептических препаратов: терафузон, присыпка Островского (перманганат калия с борной кислотой
поровну), присыпка Плахотина (борная кислота 5 г, йодоформ 2 г, сульфазол 2 г, перманганат калия 0,5 г ) присыпка Шатрова (перманганат калия 1 г, сульфат меди 1 г, йодоформ 1 г, борная кислота 10 г).Слайд 128Препарат фиксируют легкой ватно-марлевой повязкой. Первую перевязку проводят через 2-3
дня, последующие - через 5-7 дней.
В тяжелых случаях кроме
местной обработки дополнительно вводят один из антибиотиков пролонгированного действия (дибиомицин, левотетрасульфин, левоэритромицин по 40-60 мл) или суметралин, формазин, оксимекаин по 20-40 мл в течение 3 дней, или бициллин -3(5) или другие антибиотики тетрациклинового ряда в дозе 15-20 тыс. ЕД на 1 кг массы. Слайд 129ИММУНИТЕТ И ИММУНОПРОФИЛАКТИКА. Животные, переболевшие некробактериозом, иммунитет не приобретают.
Длительный
поиск специфических препаратов в виде вакцин и сывороток не принес
должного результата.Имеются экспериментальные вакцины такие как ПАМАВАК, гидроокись алюминиевая, нековак-стимул вакцина, эмульсин-вакцина, которые в производственных условиях не всегда дают желаемый результат.
Слайд 130ВАКЦИНА ИНАКТИВИРОВАННАЯ АССОЦИИРОВАННАЯ ПРОТИВ НЕКРОБАКТЕРИОЗА КОНЕЧНОСТЕЙ КРУПНОГО РОГАТОГО СКОТА «НЕКОВАК»
ВАКЦИНА ПРОТИВ НЕКРОБАКТЕРИОЗА ЖИВОТНЫХ ИНАКТИВИРОВАННАЯ
Слайд 131ПРОФИЛАКТИКА И МЕРЫ БОРЬБЫ.
Для профилактики некробактериоза в основе должны
лежать общие ветеринарно-санитарные мероприятия, направлены на все звенья эпизоотической цепи.
При
массовом распространении болезни проводят обработку конечностей животных в ваннах с 10%-м раствором сульфата меди или 5%-м раствором формалина или в "сухих" ваннах. Проводят дезинфекцию животноводческих помещений, периодичность которой зависит от интенсивности эпизоотического процесса.
Слайд 134Животноводческую ферму (бригаду отделение, хозяйство), в которой установлен некробактериоз животных,
объявляют неблагополучной по некробактериозу и вводят ветеринарные ограничения, а признают
оздоровленной в стойловый период через месяц после последнего случая выздоровления или убоя больных, при выполнении мероприятий, предусмотренных инструкцией.Слайд 135В неблагополучном по некробактериозу стаде всех больных животных выделяют в
отдельную группу и подвергают лечению.
В условно здоровом стаде ежедневно
проводят тщательный клинический осмотр, выявленных больных животных изолируют. Слайд 136Принимают меры к устранению всех возможных мест и источников травматизма,
а также мацерации кожи и размягчения рога копыт.
Проводится ежедневный
контроль состояния полов в помещениях, выгулов, территории фермы, оборудования и немедленно устраняются выявленные недостатки, которые могут быть причиной травмы. Особое внимание уделяют местам интенсивного движения поголовья (прогоны, преддоильные и доильные площадки и т.п.).
Слайд 137В животноводческих помещениях, скотопрогонах, доильных залах проводят профилактическую, а в
неблагополучных пунктах текущую и перед снятием ограничений заключительную дезинфекцию в
соответствии с инструкцией по проведению ветеринарной дезинфекции, дезинсекции, дератизации.Для дезинфекции применяют: 3%-й раствор едкого натра , 5%-й раствор формальдегида.
Слайд 138НЕКРОБАКТЕРИОЗ ЧЕЛОВЕКА
Заражение человека происходит через микротравмы на коже и наружных
слизистых оболочках в момент контакта с больными животными. Возможно также
заражение в результате употребления в пищу загрязненных микробом пищевых продуктов.Естественная восприимчивость людей невысокая. Распространение болезни носит повсеместный характер. В основном регистрируются спорадические случаи. Заболевания преобладают среди сельских жителей, профессионально или в быту связанных с животноводством.
Слайд 139Продолжительность инкубационного периода 3 - 8 дней. В месте проникновения
возбудителя образуются багровые уплотнения, затем в центре их формируется язва
с некротическим дном черного цвета. Развиваются отек и воспаление регионарных лимфоузлов. Иногда температура тела повышается до 39 - 40ºС.Болезнь может протекать в виде воспаления суставов, пневмонии, заражения крови с абсцессами во внутренних органах.
При наружных формах проявления болезни прогноз благоприятный, при генерализованных может осложняться.